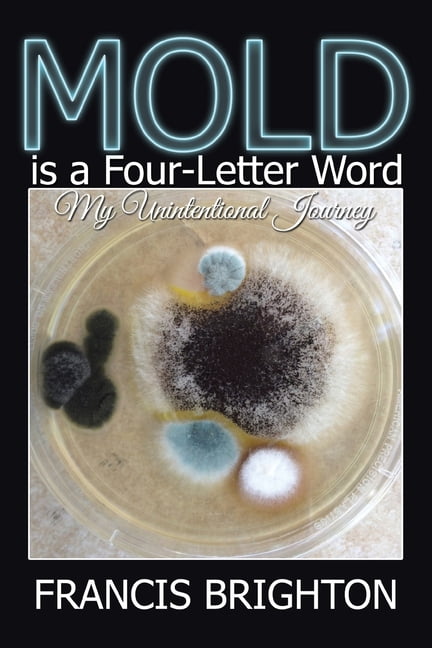

44 brighton rock author crossword
Brighton Rock Author Crossword Clue Please find below all Brighton Rock author crossword clue answers and solutions for The Guardian Quick Daily Crossword Puzzle. You have landed on our site then most probably you are looking for the solution of Brighton Rock author crossword. You've come to the right place! Our staff has just finished solving all today's The Guardian Quick ... crosswordeg.com › rock-used-to-start-a-fireRock used to start a fire Crossword Clue Answers, Crossword ... Feb 01, 2022 · This crossword clue Rock used to start a fire was discovered last seen in the February 1 2022 at the NY Times Mini Crossword. The crossword clue possible answer is available in 5 letters. This answers first letter of which starts with F and can be found at the end of T.
"BRIGHTON ROCK" AUTHOR - crossword answers, clues ... '"BRIGHTON ROCK" AUTHOR' is a 20 letter phrase starting with " and ending with R Crossword clues for '"BRIGHTON ROCK" AUTHOR' Synonyms, crossword answers and other related words for "BRIGHTON ROCK" AUTHOR [greene] We hope that the following list of synonyms for the word greene will help you to finish your crossword today.

Brighton rock author crossword
animals.howstuffworks.com › birds › starlingThe Secrets and Science Behind Starling ... - HowStuffWorks Aug 09, 2019 · Think of a rock show, you have the rock star in the front and he starts clapping his hands, and the whole stadium starts clapping," Pesendorfer says. "But these murmurations are actually self-organized, meaning that it's the individual's little behavioral rules that make it scale up to the large group. Brighton Rock author crossword clue - DailyWordAnswers.org Brighton Rock author crossword clue.This question was published at daily the sun crosswords . Solving Crossword Puzzles can help us out to release stress, maintain social bonds, and improve our vocabulary, that's why we recommend crossword puzzles to every age group. Greene, author of Brighton Rock - crossword puzzle clues ... ____ Greene, author of Brighton Rock. Today's crossword puzzle clue is a general knowledge one: ____ Greene, author of Brighton Rock. We will try to find the right answer to this particular crossword clue. Here are the possible solutions for "____ Greene, author of Brighton Rock" clue. It was last seen in British general knowledge crossword.
Brighton rock author crossword. Forename of the author of Brighton Rock - Crossword clues ... Forename of the author of Brighton Rock. Let's find possible answers to "Forename of the author of Brighton Rock" crossword clue. First of all, we will look for a few extra hints for this entry: Forename of the author of Brighton Rock. Finally, we will solve this crossword puzzle clue and get the correct word. GRAHAM -, AUTHOR - crossword answers, clues, definition ... Synonyms, crossword answers and other related words for GRAHAM -, AUTHOR [greene] We hope that the following list of synonyms for the word greene will help you to finish your crossword today. We've arranged the synonyms in length order so that they are easier to find. 6 letter words GREENE. Definition of greene. English novelist and Catholic ... Brighton Rock author Crossword Clue - Crossword Buzz The crossword clue 'Brighton Rock author' published 6 time⁄s and has 1 unique answer⁄s on our system. Check out 'The Sun Two Speed' answers for TODAY! nyxcrossword.com › 2021/12/1214-21-ny-times1214-21 NY Times Crossword 14 Dec 21, Tuesday - NYXCrossword.com Dec 14, 2021 · Graham Greene was a writer and playwright from England. Greene wrote some of my favorite novels, including “Brighton Rock”, “The End of the Affair”, “The Confidential Agent”, “The Quiet American” and “Our Man in Havana”. Greene’s books often feature espionage in exotic locales.
Brighton Rock author crossword clue ... Brighton Rock author crossword clue - TheSunCrosswordAnswers.co.uk Brighton Rock author Brighton Rock author is a crossword clue for which we have 1 possible answer and we have spotted 2 times in our database. This crossword clue was last seen on 07 January 2021 in The Sun Coffee Time Crossword puzzle! Possible Answer G R E E N E "BRIGHTON ROCK" AUTHOR - 6 Letters - Crossword Solver Help Likely related crossword puzzle clues "Brighton Rock" author "Brighton Rock" novelist ''Brighton Rock'' writer and others English actress who played Rose in 1948 film drama Brighton Rock Nibble at a bit of Brighton rock? "Baby ...," movie which features Queen's "Brighton Rock" David —, author of novels Changing Places and Author, Author "Author! The Sun Coffee Time Crossword February 27 2022 Answers ... Balkan nation crossword clue Bewitch crossword clue Brighton Rock author crossword clue Bring up crossword clue Business leader crossword clue Camp convenience crossword clue Chaplain crossword clue Clothing item crossword clue Corporation crossword clue Daze or shock crossword clue Destructive wind crossword clue Disreputable crossword clue ... Graham ___, 'Brighton Rock' author - crossword puzzle ... Graham ___, 'Brighton Rock' author. Today's crossword puzzle clue is a quick one: Graham ___, 'Brighton Rock' author. We will try to find the right answer to this particular crossword clue. Here are the possible solutions for "Graham ___, 'Brighton Rock' author" clue. It was last seen in British quick crossword. We have 1 possible answer in our ...
brighton rock author, graham ___ (6)/889168 Crossword Clue ... The Crossword Solver found 20 answers to the brighton rock author, graham ___ (6)/889168 crossword clue. The Crossword Solver finds answers to American-style crosswords, British-style crosswords, general knowledge crosswords and cryptic crossword puzzles. Enter the length or pattern for better results. Click the answer to find similar crossword clues. Novelist Graham - crossword puzzle clue Novelist Graham is a crossword puzzle clue. Clue: Novelist Graham. Novelist Graham is a crossword puzzle clue that we have spotted 10 times. There are related clues (shown below). Brighton Rock author Crossword Clue, Crossword Solver ... The Crossword Solver found 20 answers to the Brighton Rock author crossword clue. The Crossword Solver finds answers to American-style crosswords, British-style crosswords, general knowledge crosswords and cryptic crossword puzzles. Enter the length or pattern for better results. Click the answer to find similar crossword clues. "Brighton Rock" novelist Crossword Clue Answers "Brighton Rock" novelist crossword clue? Find the answer to the crossword clue "Brighton Rock" novelist. 1 answer to this clue. Crossword Clue Solver - The Crossword Solver. Home; ... Author of "The Third Man, Conclusion of tale by young writer English novelist putting area first for excellence English novelist, Graham, d. 1991.
› cultureCulture: Music, TV & radio, books, film, art ... - The Telegraph All the latest news, reviews, pictures and video on culture, the arts and entertainment.
Brighton Rock author (6) Crossword Clue, Crossword Solver ... The Crossword Solver found 20 answers to the Brighton Rock author (6) crossword clue. The Crossword Solver finds answers to American-style crosswords, British-style crosswords, general knowledge crosswords and cryptic crossword puzzles. Enter the length or pattern for better results. Click the answer to find similar crossword clues.
"Baby ...," Movie Which Features Queen'S "Brighton Rock ... We have found 1 Answer (s) for the Clue „"Baby ...," movie which features Queen's "Brighton Rock"". Try to find some letters, so you can find your solution more easily. If you've got another answer, it would be kind of you to add it to our crossword dictionary.
› author › AmericanBrowse Listings - rochestercitynewspaper.com Rochester's Alternative Newsmonthly. Reimagine Policing @ Rochester Brainery This class will explore what the abolition of the criminal justice system...
› author › BarnhillBrowse Listings - rochestercitynewspaper.com Rochester's Alternative Newsmonthly. Comedy Improv Workshop @ Central Creatives Co-Work of Art Writer and improvisor Joanne Brokaw, author of "Suddenly Stardust: A Memoir (of...
Brighton Rock author - crossword puzzle clues & answers ... Brighton Rock author. Today's crossword puzzle clue is a quick one: Brighton Rock author. We will try to find the right answer to this particular crossword clue. Here are the possible solutions for "Brighton Rock author" clue. It was last seen in Daily quick crossword. We have 1 possible answer in our database.
BATHROOM, IN BRIGHTON - 3 Letters - Crossword Solver Help Search for crossword clues found in the NY Times, Daily Celebrity, Daily Mirror, Telegraph and major publications. ... "Brighton Rock" author. Poor house for a student near part of Brighton actually. Old fools point poets away from Brighton's front. Doctor in Brighton.
Brighton Rock author crossword clue Brighton Rock author is a 3 word phrase featuring 20 letters. We most recently saw this clue in 'The Sun Cryptic' on Thursday, 07 January 2021 with the answer being GREENE, we also found GREENE to be the most popular answer for this clue. We've seen this clue in the following publications: The Sun Cryptic - 7 Jan 2021. Crossword Answers.
"Brighton Rock" novelist - crossword puzzle clue Clue: "Brighton Rock" novelist "Brighton Rock" novelist is a crossword puzzle clue that we have spotted 3 times. There are related clues (shown below). Referring crossword puzzle answers GREENE Likely related crossword puzzle clues Sort A-Z Novelist Graham Graham or Lorne "The Quiet American" author 'Bonanza' star "Bonanza" star
en.wikipedia.org › wiki › DiacriticDiacritic - Wikipedia A diacritic (also diacritical mark, diacritical point, diacritical sign, or accent) is a glyph added to a letter or to a basic glyph. The term derives from the Ancient Greek διακριτικός (diakritikós, "distinguishing"), from διακρίνω (diakrī́nō, "to distinguish").
brighton rock author, graham ___ (6) Crossword Clue ... The Crossword Solver found 20 answers to the brighton rock author, graham ___ (6) crossword clue. The Crossword Solver finds answers to American-style crosswords, British-style crosswords, general knowledge crosswords and cryptic crossword puzzles. Enter the length or pattern for better results. Click the answer to find similar crossword clues.
Brighton Rock Author - Crossword Clue Answers - Crossword ... The crossword clue Brighton Rock author with 6 letters was last seen on the January 07, 2021. We think the likely answer to this clue is GREENE. Below are all possible answers to this clue ordered by its rank. You can easily improve your search by specifying the number of letters in the answer.
Brighton Rock writer, Graham ... Crossword Clue, Crossword ... The Crossword Solver found 20 answers to the Brighton Rock writer, Graham ... crossword clue. The Crossword Solver finds answers to American-style crosswords, British-style crosswords, general knowledge crosswords and cryptic crossword puzzles. Enter the length or pattern for better results. Click the answer to find similar crossword clues.
Brighton Rock author - Crossword clues & answers - Global Clue Brighton Rock author. Let's find possible answers to "Brighton Rock author" crossword clue. First of all, we will look for a few extra hints for this entry: Brighton Rock author. Finally, we will solve this crossword puzzle clue and get the correct word. We have 2 possible solutions for this clue in our database.
Brighton Rock author - Crossword Clue, Answer and Explanation Brighton Rock author - Crossword Clue, Answer and Explanation Brighton Rock author (6) On your phone - wherever you are, Crossword Genius is the ideal tool to help beginners learn cryptic crosswords I believe the answer is: greene 'brighton rock author' is the definition. (I've seen this before) This is all the clue.
"Brighton Rock" author Crossword Clue Answers Below are possible answers for the crossword clue "Brighton Rock" author. 6 letter answer(s) to "brighton rock" author. GREENE. English novelist and Catholic (1904-1991) Other crossword clues with similar answers to '"Brighton Rock" author' "Brighton Rock" novelist "The End of the Affair" a
Greene, author of Brighton Rock - crossword puzzle clues ... ____ Greene, author of Brighton Rock. Today's crossword puzzle clue is a general knowledge one: ____ Greene, author of Brighton Rock. We will try to find the right answer to this particular crossword clue. Here are the possible solutions for "____ Greene, author of Brighton Rock" clue. It was last seen in British general knowledge crossword.
Brighton Rock author crossword clue - DailyWordAnswers.org Brighton Rock author crossword clue.This question was published at daily the sun crosswords . Solving Crossword Puzzles can help us out to release stress, maintain social bonds, and improve our vocabulary, that's why we recommend crossword puzzles to every age group.
animals.howstuffworks.com › birds › starlingThe Secrets and Science Behind Starling ... - HowStuffWorks Aug 09, 2019 · Think of a rock show, you have the rock star in the front and he starts clapping his hands, and the whole stadium starts clapping," Pesendorfer says. "But these murmurations are actually self-organized, meaning that it's the individual's little behavioral rules that make it scale up to the large group.

0 Response to "44 brighton rock author crossword"
Post a Comment